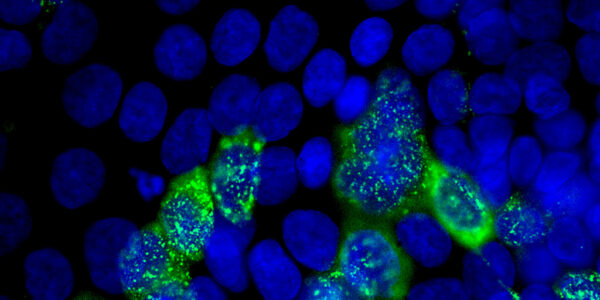
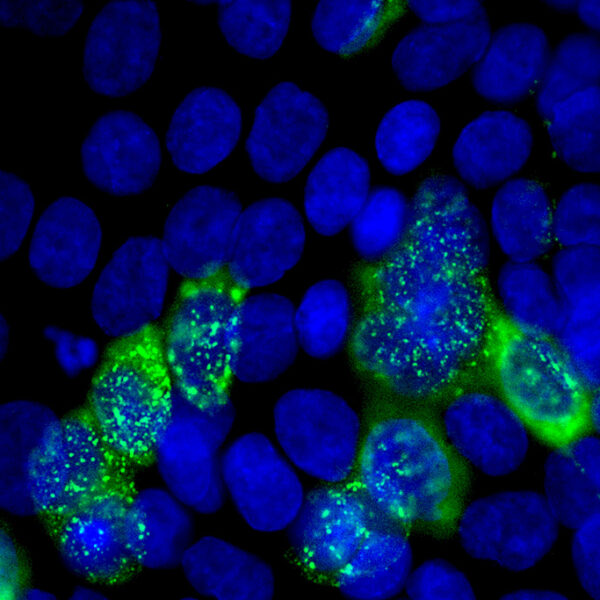

Un grupo de investigación mostró que el Imiquimod, un fármaco que se utiliza para tratar las verrugas genitales provocadas por el virus del papiloma humano (HPV), inhibe la replicación del SARS-CoV-2 y del coronavirus canino. Ya habían demostrado que también actúa sobre el virus sincicial respiratorio, responsable de la bronquiolitis.